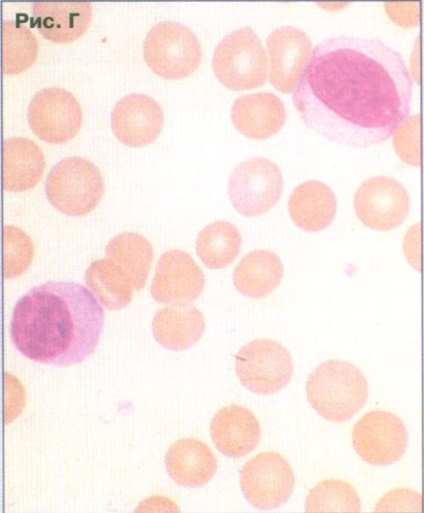

MMA. IMSechenov
La velichenie dimensiunii ganglionilor limfatici (LU) - limfadenopatie - este un simptom al multor boli difera in cauza lor, manifestările clinice, metodele de diagnostic, tratament și prognostic.
boli majore cu sindrom limfadenopatie
infecție
• bacteriene (toate bacteriile piogenice, boala
pisica zero, sifilis, tularemia)
• mycobacteriene (tuberculoza, lepra)
• fungică (histoplasmoza, coccidioidomicoza)
• chlamydia (LGV)
• parazitara (toxoplasmoza, tripanozomiazei, filarioza)
• Virusul virale (Epstein-Barr, citomegalovirus,
rujeola, hepatita, HIV)
Situațiile în care a arătat o creștere a ganglionilor limfatici periferici
- DR este detectată de o creștere a pacienților care suferă de boala (prezent sau trecut), care se manifesta limfadenopatie;
- creștere LU doctor detectat la un pacient care suferă de boală limfadenopatie (prezent sau trecut) și a solicitat alte motive (febră, durere etc.);
- creșterea în LU este detectat medicul pacientul nu suferă în boala din trecut cu limfadenopatie și a solicitat pentru alte motive.
- Direcția de căutare de diagnosticare cu limfadenopatie este determinată în primul rând de situația clinică; informațiile obținute în timpul examinării inițiale a pacientului (anamneza, examenul fizic), datele studiilor de laborator de rutină, în principal, indicatori de sânge periferic.
Diagnosticul diferențial al repere de bază limfadenopatie obținute la examinarea inițială a pacienților, sunt:
- de vârstă a pacienților;
- anamneza;
- limfadenopatie caracter (localizare, prevalență, dimensiuni, consistență, sensibilitate, mobilitate LU);
- prezența altor semne clinice (splină mărită, febră, erupții cutanate, sindrom articulare, leziuni pulmonare, etc ..);
- sângele periferic.
boală imună
Artrita reumatoidă, lupus eritematos sistemic. Boala serului, reacții la medicamente (fenitoina), boala Kastlemena (hiperplazie limfoidă angiofollikulyarnaya), histiocitoza sinusală cu limfadenopatie masiva, sindromul Kawasaki, boala Kimura (găsit în Asia).
Tumorile sistemului imunocompetente
mieloide și limfoide leucemii acute si cronice, limfom non-Hodgkin, boala Hodgkin, limfom angioimmuno blastopodobnaya cu celule T, macroglobulinemia Waldenstrom, mielom multiplu cu amiloidoză, histiocitoză malignă.
Alte tumori (metastaze)
Cancerul de sân, pulmonar; melanom; tumori ale capului și gâtului; tumori ale tractului gastro-intestinal; sarcomul Kaposi; tumori ale celulelor germinale.
boli de stocare
Boala Gaucher, Niemann-Pick.
endocrinopathy
Hipertiroidism, tiroidită, insuficiență suprarenală.
alte
Sarcoidoza, amiloidoza (mielom, amioidoz ereditar, boli inflamatorii cronice), lymphadenitis dermatopatichesky.
Înainte de un medic apare problema de diagnostic în primul rând diferențială, a cărei soluție determină tactici de gestionare a pacientului (Fig. 1).
Fiecare dintre aceste caracteristici are o valoare diferită de diagnosticare (sensibilitate, specificitate). Astfel, febra si anemie limfadenopatie pacient ar putea fi nu numai o manifestare a procesului infecțios și neoplazic, dar, de asemenea, anumite vasculita sistemica (lupus eritematos sistemic, boala Still, și altele.). În același timp, dezvăluind în celulele blastice din sângele periferic indică aproape sigur prezența pacienților cu leucemie acută și are nevoie de o clarificare a variantei morfologice.
Vârsta pacienților poate fi unul dintre punctele de referință pentru a ghida căutarea de diagnostic, deoarece un număr de boli care se manifesta limfadenopatie, are o anumită „vârstă de atașament.“ Este cunoscut faptul că mononucleoza infecțioasă este mai frecventa in copilarie si adolescenta, si leucemie limfocitară cronică - persoanele în vârstă și persoanele în vârstă. În același timp, vârsta pacientului, desigur, nu poate fi decisiv, și este doar unul dintre reperele de căutare de diagnosticare.
Fig. 1. opțiuni principale limfadenopatiei.

Fig. 2. Algoritmul de căutare de diagnosticare la limfadenopatie regională sau locală.

1 Dificultăți de diagnostic diferential la limfadenopatia local sau regional sunt în primul rând în capacitatea de a identifica procesul inflamator local infecțioase (de multe ori) sau neinfecțioase natura si sa se asocieze patologia locală identificată cu creșterea aria corespunzătoare LU.
Cea mai mare parte a procesului inflamator local, însoțită de o creștere a LU regionale, privind identificarea, care ar trebui să fie orientate medic, sunt după cum urmează:
• amigdalită acută (tonzillofaringit)
• stomatită,
• otita medie,
• eczeme feței, extremităților,
• conjunctivită
• tromboflebită acută a extremităților,
• erizipel (o persoană care, desigur)
• fierbe, furunculelor,
• felon,
• zgârieturi, mușcături,
• inflamație a organelor genitale.
La identificarea procesului inflamator local la pacienții cu o creștere în situația LU regională este considerată limfadenitå reactivă. Metode de citologice și diagnostic histologic în faza acută a bolii oferă puține informații din cauza dificultăților în interpretarea imaginii morfologice a fundalului hiperplaziei reactivă a țesutului limfatic. Pentru verificarea finală a naturii limfadenopatie este necesară pentru a evalua dinamica inflamației locale, și limfadenopatie regională privind tratamentul de fond (antibiotice, tratament chirurgical).
Pentru verificarea finală a naturii limfadenopatie dinamicii necesare procesului inflamator local și limfadenopatie regională privind tratamentul de fond (antibiotice, tratament chirurgical). În cazurile de creștere persistentă în Letonia, în ciuda regresia procesului inflamator local, mai ales în prezența unui LU consistență densă, LU este o biopsie pentru examinare histologică.
3 Printre metodele de rutină de laborator pentru diagnosticul diferențial al pacienților cu limfadenopatie este studiul obligatoriu al sângelui periferic. Scopul acestui studiu este de a confirma sau exclude un diagnostic prezumtiv în etapa examinării inițiale a pacientului. În evaluarea și interpretarea modificărilor observate în sângele periferic este necesar să se țină seama de specificitatea lor inegale. Astfel, limfocitoză absolută persistentă cu prezența celulelor coș de celule este semne de laborator patognomonice de leucemie limfocitară cronică, și prezența celulelor blastice în sânge poate indica fie leucemie limfo-explozie sau un leukemization limfom. Astfel de caracteristici ca leucocitoza, leucopenie (neutropenie), trombocitopenie, nu sunt specifice, așa cum poate avea loc la o gama larga de boli care implica limfadenopatie.
3 identificate în timpul examinării fizice a pacientului limfadenopatia diverse semne clinice suplimentare pot deveni cheie în procesul de căutare diagnostic diferențial. Astfel, prezența femeilor tinere, odată cu creșterea simptomelor LU, cum ar fi febra, artralgii, erupții cutanate, pleurezie, trebuie sa ridice suspiciunea de lupus eritematos sistemic, care determină direcția de căutare de diagnosticare. Limfadenopatie este una dintre manifestările extra-articulare la pacienții cu artrită reumatoidă, și de obicei nu necesită specificarea cauzelor sale. Cu toate acestea, trebuie să ținem cont de posibilitatea de a limfoamelor maligne în poliartrita reumatoidă, și, prin urmare, în anumite situații, pot exista indicii pentru biopsie LU pentru a exclude limfom.
Tabelul 1. Schimbări majore în sângele periferic al pacienților cu limfadenopatie asociate cu diverse boli
Modificări în sângele periferic
Fig. 4. Valoarea de diagnostic a caracteristicilor suplimentare la pacientii cu limfadenopatie.

1 mononucleoza infecțioasă - o boală virală cauzată de virusul Epstein-Barr. Bolnavi de persoane mai des tineri. Principalele manifestări clinice sunt crescute marimea LU, febra, rezistența la antibiotice, papulară cutanată, splenomegalie, amigdalită acută, semnele clinice și de laborator de leziuni hepatice. Limfadenopatie poartă de obicei un caracter regional pentru a învinge zadnesheynyh LU, dureros la palpare. Cu toate acestea, este posibil și generalizată creștere în Letonia, inclusiv bronhopulmonar. antibioticele sunt numiți în legătură cu febra ineficiente, adesea observate la pacienții cu hipersensibilitate la antibiotice, în special aminopeniciline. Prezența febră, erupții cutanate și, uneori, icter (hepatită) este de multe ori motivul pentru spitalizare a pacienților în departamentul infecțioase.
De multe ori crește splina, care devine sensibil la palpare. O caracteristică a splenomegaliei în mononucleoza infecțioasă este o tendință de ruptură a splinei sau leziuni minore spontane, inclusiv grosier și palparea persistentă (vezi. Fig. A). În sânge, de multe ori a relevat leucocitoză moderată cu cantități crescute de limfocite cu citoplasmă larg bazofile (vezi. Fig. B), prezența celulelor plasmatice. Nivelul hemoglobinei și numărul de trombocite nu sunt modificate, cu excepția cazurilor rare de citopenii autoimune. Suspiciune de mononucleoză infecțioasă, necesită de obicei expectativă, observarea pacientului, tratament simptomatic. În faza acută, în absența unor indicații specifice ar trebui să se abțină de la o cercetare osoasă biopsie de măduvă și LU. Diagnosticul poate fi verificată utilizând metoda de examinare virusologică a reacției în lanț a polimerazei. Recuperarea este uneori întârziată, dar prognosticul este în general favorabil.

2 boala Still la adulți este o variantă de boli sistemice ale tesutului conjunctiv, manifestate prin febra, rezistența la antibiotice, în creștere DR și splină, piele și hemoragica papulară, sindromul articular (artralgie, artrita mai puțin). În sângele periferic caracterizat prin leucocitoză, creșterea ratei de sedimentare a eritrocitelor. Boala este cel mai adesea diferențiate de lupus eritematos sistemic, artrită reumatoidă, hepatită virală cu manifestări sistemice, proces septic. Metodele specifice de diagnostic nu există. Examinarea histologică a LU oferă puține informații. efectul clinic sub formă de relief de febra si alte simptome pot fi observate în numirea de glucocorticoizi.
3 hepatita virală cronică (adesea cu virusul hepatitei C), se poate manifesta în diverse simptome extrahepatice (febra, limfadenopatia, hemoragica vasculita, leziuni pulmonare, poliserozită, sindromul Sjogren). In unele cazuri, simptomele extrahepatice vine în prim-plan în tabloul clinic și este debutul bolii hepatice. Dacă suspectați că hepatita virală cronică teste de laborator necesare pentru prezența markerilor hepatitei B. Pentru verificarea finală examenul histologic recomandabil probelor biopsie hepatică.

4 Boala Gaucher si Niemann -Pick aparțin așa-numitele boli de stocare, care se bazează pe un defect ereditar în metabolismul fosfolipide și cerebrozide. Celulele mononucleare fagocitare și LU splina proliferează rapid si fagocita lipidelor nemetabolizat. proliferarea celulară intensivă macrofage crește LU și, în principal splina. Exprimate cu citopenie splenomegalia este un marker clinic al bolii. De aceea, identificarea pacienților cu limfadenopatie creștere semnificativă în splină, în absența altor cauze necesită boala de stocare de excludere, în special boala Gaucher. caracteristica de diagnosticare este prezența celulelor așa-numite Gaucher în punctates LU, măduva osoasă, splină. Celulele au un miez dens dispus excentric si citoplasmatici gri deschis striații concentrice (vezi. Fig. B). Posibila verificare a deficienței enzimei glucocerebrozidaza, care prevede utilizarea lipidelor în leucocite din sângele periferic.

5 macroglobulinemia Waldenstrom se referă la leucemie cronică, al cărui principal substrat sunt celule limfoide mature si mature. O caracteristică a bolii este producerea de celule limfoide tumorale monoklonovogo proteină - macroglobulina aparținând clasei IgM, care se poate dezvolta ca urmare a unor leziuni vasculare (vasculita). Principalele manifestări clinice ale bolii, impreuna cu limfadnopatiey sunt splenomegalie, leziuni cutanate hemoragice, prezenta simptomelor urinare. În sânge (vezi. Fig. D) a relevat o limfocitoză absolută, anemie (de multe ori din cauza hemoliza autoimună), o creștere semnificativă a ESR. In maduva osoasa de infiltrare limfoidă. Diagnosticul este confirmat de prezența unui pacient cu splina marita si LN macroglobulina IgM.
6 limfadenopatia Medicinal poate rezulta din sistemul de reacție lymphohistiocytic unele medicamente (fenitoina, preparate aur).

7 sarcoidoza - inflamație granulomatoasă, manifestată clinic prin creșterea LU (adesea bronhopulmonară, rar periferică), leziuni ale plămânilor și a altor organe. O caracteristică a pacienților cu sarcoidoză este depresia imunității celulare care manifestă o reacție negativă la injectarea intradermică de tuberculină (testul cutanat cu tuberculină negativ). Sarcoidoza substratul morfologic este granulomul sarcoid (vezi. Fig. D) constând din limfoidă, celule epiteloide, celule gigant Pirogov-Langhans în absența (în contrast cu t la tuberculină granulomul Kuleznev) necroză cazeoasă.
8 limfadenopatie angioimmunoblastic.
Tabelul 2. Diagnosticul diferențial în tumorile limfoproliferative